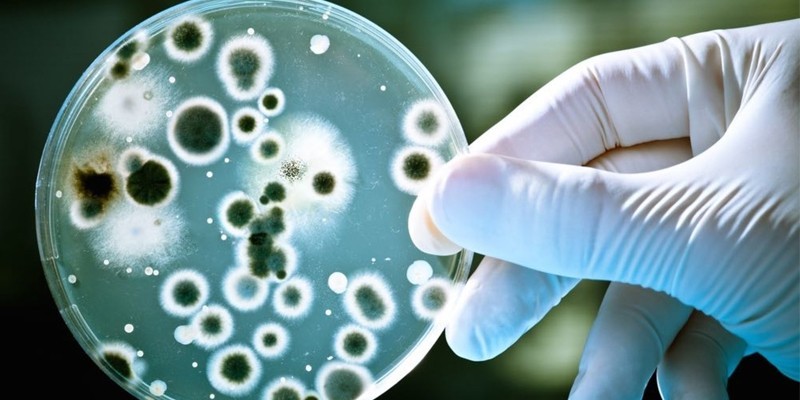
image

Инфекционное заболевание туберкулез характеризуется поражением легких, мочеполовой системы, костей, органов ЖКТ, кожи. Туберкулез вызывают микроорганизмы, относящиеся к роду Mycobacterium, которые еще называют палочкой Коха. Микобактерии имеют около 100 разновидностей, широкую распространенность в мире благодаря устойчивости к внешним воздействиям.
Характеристика возбудителя
Палочки Коха являются анаэробными бактериями, живущими в присутствии кислорода. Это становится причиной того, что инфекция чаще поражает легкое. Возбудителя туберкулеза характеризуют такие особенности:
- клетка состоит из трех слоев, защищающих ее от повреждений, химического воздействия;
- ее стенка покрыта плотным восковым слоем, что мешает использовать красители при диагностике;
- размножение происходит бесполым способом, путем деления клетки пополам;
- микобактерия имеет длину до 10 мкм, ширину – до 2,5 мкм.

Туберкулезная палочка отличается высокой приспособляемостью к внешним условиям, повышенной живучестью. Возбудители туберкулеза обладают такими свойствами:
- патогенность – провоцируют развитие инфекции;
- иммуногенность – имеют способность вызывать иммунный ответ;
- вирулентность – заражают организм-хозяин, размножаясь в нем, вызывая поражение органов;
- изменчивость – теряют прежние свойства, приобретают необычные качества, приспосабливаясь к новым условиям.
Пути заражения
Источником заболевания могут быть люди, который перенесли инфекцию. Заражение нередко происходит в местах большого скопления народа – в школах, общежитиях, тюрьмах. Особую опасность представляет открытая форма туберкулеза. Подхватить инфекцию можно при контактах:
- с больным человеком;
- с зараженным животным.
Существует несколько путей инфицирования:
- Воздушно-капельный – самый распространенный. Передача возбудителя происходит при разговоре, чихании, через слюну, дыхание.
- Алиментарный – в случае употребления зараженных микобактериями продуктов питания.
- Контактный – при использовании общей с больным посуды, одежды, при поцелуях.
- Внутриутробный – редкое явление. Возбудитель попадает от инфицированной матери к плоду.
Статьи по теме
- Туберкулез кожи – первые признаки, виды и проявления болезни, способы терапии
- Туберкулезный менингит у детей – признаки, диагностика, терапия и осложнения
- Последствия плеврита легких и профилактика осложнений
Устойчивость во внешней среде
Благодаря особому устройству клетки палочки Коха, она оказывает противодействие внешней агрессивной среде. Возбудители туберкулеза показывают устойчивость к химическим веществам, колебанию температуры, отсутствию воды. Они сохраняют свойства в случае:
- действия кислоты, щелочи, спирта;
- обработки дезинфицирующими средствами;
- высохшей мокроты – необходимо 45 минут кипячения для гибели микобактерий.
Микроорганизмы, вызывающие туберкулез, показывают такую жизнестойкость:
- Могут существовать при условиях: пыли – 20 дней; помойной ямы – полгода; в воде – 150 суток.
- Теряют жизнеспособность: при температуре 50 градусов через 12 часов; под действием ультрафиолетового излучения спустя 30 минут; в растворе хлорной извести 2% через двое суток; могут погибать на солнце через 6 часов.
Мнение врача:
Возбудителем туберкулеза являются бактерии рода Mycobacterium, в основном Mycobacterium tuberculosis. Эти бактерии передаются воздушно-капельным путем при контакте с инфицированным человеком, особенно при кашле или чихании. Врачи подчеркивают, что туберкулез остается серьезной проблемой общественного здоровья, и необходимо соблюдать профилактические меры, такие как вакцинация, соблюдение гигиены и своевременное обращение к врачу при появлении симптомов заболевания.

Виды
Современная наука насчитывает 74 разновидности микобактерий. Они распространены среди людей, животных, находятся в земле, воде. Туберкулез вызывают три основных типа микроорганизмов:
|
Возбудитель |
К какому виду относится |
Процент поражения человека |
Видовой признак |
Особенности |
|
Mycobacterium tuberculosis |
человеческому |
92–97 |
Микобактерии бычьего типа менее патогенны, при ниациновом тесте выделяют больше никотиновой кислоты (ниацина) |
|
|
Mycobacterium bovis |
бычьему |
5 |
Чаще поражает крупный рогатый скот У человека вызывает туберкулез лимфоузлов, костей |
|
|
Mycobacterium africanum |
промежуточному |
3 |
Болеют жители Африки |
Интересные факты
- Возбудитель туберкулеза – туберкулезная палочка (Mycobacterium tuberculosis) – был впервые выделен и описан Робертом Кохом в 1882 году. Кох также создал первый тест на кожную чувствительность к туберкулезу, который используется до сих пор.
- Туберкулез передается воздушно-капельным путем при вдыхании инфицированных воздушных капель, содержащих бактерии. Риск заражения наибольший при нахождении вблизи человека больного открытой формой туберкулеза, который выделяет большое количество бактерий при кашле или чихании.
- Туберкулез может поражать различные органы и ткани, чаще всего легкие, но также может распространяться на лимфатические узлы, почки, кости, суставы, кожу и т. д. Туберкулез в легких также могут вызывать бычий тип (Mycobacterium bovis) и птичий тип (Mycobacterium avium) бактерий, которые в основном встречаются у животных.
Бактериальное носительство
Человек, однажды переболевший туберкулезом, становится пожизненным носителем инфекции. Микобактерии после первичного заражения остаются в организме, удалить их практически невозможно. Спровоцировать переход латентной стадии заболевания к активной фазе могут:
- резкое снижение иммунитета;
- влажность помещения;
- сахарный диабет;
- хронические патологии органов пищеварения;
- курение.
Заболевание нередко развивается как результат контактов с больным человеком. По данным статистики, носительство туберкулеза среди взрослого населения составляет около 80%. Распространение инфекции нередко провоцируют:
- плохие условия проживания;
- низкий материальный достаток;
- отсутствие гигиены;
- социально-экономическая ситуация;
- иммунодефицитные состояния;
- работа во вредных условиях;
- беспорядочные половые связи.

Опыт других людей
Возбудитель туберкулеза – это бактерии рода Mycobacterium tuberculosis, которые вызывают данное заболевание. Они могут передаваться воздушно-капельным путем при разговоре, кашле или чихании инфицированного человека. Люди, сталкиваясь с туберкулезом, отмечают его высокую заразность и способность вызывать серьезные осложнения. Важно соблюдать профилактические меры и обращаться за медицинской помощью при подозрении на заболевание.
Способы выявления возбудителя туберкулеза
Диагностика заболевания проводится лабораторными методами исследования. Чтобы выявить возбудителя инфекции применяют несколько способов. Среди них результативными считают:
- исследование крови – определяет наличие воспаления, отмечают лейкоцитоз, увеличение СОЭ;
- микроскопический анализ мокроты по окрашиванию жидкости – обнаружение в мазке более 5 микобактерий говорит об инфицировании;
- проба Манту – при ведении подкожно туберкулина в случае туберкулеза появляется кожная реакция – очаг инфильтрации.
Видео
Внимание!
Информация, представленная в статье, носит ознакомительный характер. Материалы статьи не призывают к самостоятельному лечению. Только квалифицированный врач может поставить диагноз и дать рекомендации по лечению, исходя из индивидуальных особенностей конкретного пациента.
Частые вопросы
Какой вид бактерий вызывает туберкулез?
Mycobactérium tuberculósis (лат.), па́лочка Ко́ха (МБТ, BK) — вид микобактерий, типовой вид семейства Mycobacteriaceae, выделен 24 марта 1882 года Робертом Кохом (24 марта объявлено ВОЗ Всемирным днём борьбы с туберкулёзом).
Какие возбудители туберкулеза?
Возбудителем туберкулеза является бактерия под названием микобактерия туберкулеза (Mycobacterium tuberculosis). Другие родственные бактерии (микобактерии), такие, как Mycobacterium bovis или Mycobacterium africanum, могут вызывать похожие заболевания.
Какой путь заражения характерен для туберкулеза?
Всего выделяют четыре классических пути передачи туберкулеза: аэрогенный (воздушно-капельный и воздушно-пылевой), алиментарный, через пищеварительный тракт (например, через инфицированное молоко или мясо больного животного), контактный (через конъюнктиву и поврежденную кожу) и вертикальный (от матери к плоду).
Чем вызывается туберкулез возбудитель?
Туберкулезом называют хроническое инфекционное бактериальное заболевание, вызванное возбудителем Mycobacterium tuberculosis complex (в народе более известном как палочка Коха). Впервые этот микроорганизм выделил немецкий ученый Роберт Кох в 1882 году, но сам недуг известен очень давно.
Полезные советы
СОВЕТ №1
Избегайте контакта с больными туберкулезом и по возможности избегайте посещения мест с большой концентрацией людей, чтобы уменьшить риск заражения.
СОВЕТ №2
Соблюдайте правила личной гигиены, регулярно мойте руки с мылом и водой, чтобы предотвратить передачу возбудителя туберкулеза.

